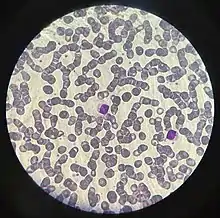

Linfocito T
Los linfocitos o células-T son linfocitos producidos en la médula ósea y que luego maduran en el timo, cuyas funciones son parte importante del sistema inmunitario adaptativo.[1] La célula inmadura se denomina timocito, el cual durante el proceso de maduración en el timo se diferencia en linfocito T cooperador (CD4+) o bien en linfocito T citotóxico (CD8+). Los linfocitos así desarrollados circulan posteriormente por la sangre y el sistema linfático hasta que son activados al contactar con un antígeno específico, el cual interactúa con el receptor de linfocitos T que hay en su superficie. Estos antígenos deben ser presentados a los linfocitos T por células presentadoras de antígenos, tales como las células dendríticas o los macrófagos mediante moléculas del complejo mayor de histocompatibilidad. De esta forma, los linfocitos T pueden responder de forma específica contra patógenos y células tumorales.[2]
| Linfocito | ||
|---|---|---|
![]() Micrografía de un linfocito T humano del sistema inmunitario de un donador sano. | ||
![]() Representación 3D de un linfocito T. | ||
| Nombre y clasificación | ||
| Sinónimos |
| |
| Latín | Lymphocytus T | |
| TH | H2.00.04.1.02007 | |
| TH | H2.00.04.1.02007 | |
| Información anatómica | ||
| Región | sangre y sistema linfático | |
| Sistema | Inmunitario | |
| Precursor | Timocito | |
|
| ||
Los linfocitos T así activados son los responsables de la inmunidad celular destruyendo células infectadas o activando macrófagos, linfocitos B u otros linfocitos T mediante citoquinas y otras proteínas coestimulatorias que se encuentran en su membrana celular. Este tipo de inmunidad requiere un contacto directo y estrecho con otras células.
Existen varios tipos de linfocitos T dependiendo de las moléculas de superficie que presenta, de las sustancias que secreta y de su función principal.
Se diferencian de los linfocitos B y de las células NK (o célula Natural Killer, en español «asesina natural») por poseer un receptor especial en la superficie de la membrana, el receptor de linfocitos T (también llamado TCR, por su denominación en inglés T cell receptor). Sin embargo, en un frotis microscópico de sangre no es posible distinguir uno de otro a simple vista.
La denominación de estos linfocitos como T se debe a que su maduración tiene lugar en el timo (órgano linfoide que constituye uno de los controles centrales del sistema inmunitario del organismo). El número de leucocitos en sangre periférica en un humano promedio es de 4 a 11 x 109 por litro, del cual, normalmente, un 20 % son linfocitos.
Los linfocitos T de un individuo concreto presentan una propiedad denominada restricción CMH: solo pueden detectar un antígeno si este viene presentado por una molécula del complejo mayor de histocompatibilidad (CMH) del mismo individuo. Esto se debe a que cada linfocito T tiene una especificidad dual: el receptor del linfocito T (TCR) reconoce algunos residuos del péptido y simultáneamente algunos residuos de la molécula CMH que lo presenta. Esta propiedad es muy importante en el trasplante de órganos, e implica que, durante su desarrollo, los linfocitos T deben aprender a reconocer las moléculas CMH propias del individuo, un proceso complejo que tiene lugar en el timo. Puesto que las moléculas CMH solo pueden presentar péptidos, esto implica que los linfocitos T, dado que solo pueden reconocer un antígeno si viene asociado a una molécula CMH, solo pueden reaccionar ante antígenos de origen proteico (procedentes de microorganismos) y no a otro tipo de compuestos químicos (ni lípidos, ni ácidos nucleicos, ni azúcares). Las moléculas CMH adquieren el péptido que presentan en el exterior de la membrana celular durante su propia biosíntesis, en el interior celular. Por tanto, los péptidos que presentan las moléculas CMH provienen de microorganismos que están en el interior celular, y esta es la razón por la cual los linfocitos T solo detectan microorganismos asociados a células y desencadenan una respuesta inmune contra microorganismos intracelulares.[3]
Tipos de linfocitos T


Se han descrito varios subtipos de células T, cada uno de ellos con una función distintiva.[4]
Linfocitos T citotóxicos
Los linfocitos T citotóxicos o linfocitos CD8+ reconocen células infectadas o transformadas y las destruyen mediante perforinas y granzimas que provocan su apoptosis.[4] Célula linfoplasmocitoide: una célula con una mezcla de características morfológicas de linfocitos B y células plasmáticas que se cree que está estrechamente relacionada o que es un subtipo de células plasmáticas. Este tipo de células se encuentra en discrasias de células plasmáticas premalignas y malignas que están asociadas con la secreción de proteínas monoclonales IgM; estas discrasias incluyen la gammapatía monoclonal IgM de importancia indeterminada y la macroglobulinemia de Waldenström.22
Linfocitos T cooperadores
Los Linfocitos T cooperadores o linfocitos CD4+ se encargan de iniciar la cascada de la respuesta inmune coordinada mediante la interacción con un complejo «péptido-CMH-II». Cuando se activan, los linfocitos CD4+ se especializan, diferenciándose a su vez en linfocitos efectores, que se distinguen por el tipo de citoquinas que producen:
- Th1, desarrollado por el efecto de la interleucina-12, que induce la activación de los macrófago mediante la secreción de interferón γ y el aumento de iNOS logrando la destrucción de patógenos intracelulares tales como la Leishmania, la Listeria monocytogenes y los Mycobacterium.[4]
- Th2, que permanecen sobre todo en los tejidos linfoides y colaboran en la activación de los linfocitos B; segregan principalmente IL-4 (que estimula la secreción de Ig-E, que a su vez activa los mastocitos) e IL-5 (que activa los eosinófilos); los Th2 son importantes en las reacciones alérgicas y en la defensa frente a parásitos.
- Th17, denominados así porque segregan IL-17, además de IL-22; son los principales mediadores en algunas reacciones alérgicas, y parecen estar implicados en el desarrollo de enfermedades como la esclerosis múltiple, la artritis reumatoide y la enfermedad inflamatoria intestinal.
La diferenciación en Th1, Th2 o Th17 no es al azar, sino que depende de los estímulos que reciba el linfocito T4 virgen cuando contacte un antígeno extraño.
Linfocitos T de memoria
Son células que se generan después de la activación de los linfocitos T, por exposición a un antígeno extraño (un patógeno). Tienen vida larga, son funcionalmente inactivos, y pueden circular durante meses o años, preparados para responder a nuevas exposiciones al mismo microorganismo. El objetivo de las vacunas es precisamente generar linfocitos de memoria (T y B) mediante la exposición a un patógeno atenuado, de manera que el organismo responda de manera rápida y eficaz frente al patógeno activo.
Linfocitos T reguladores
Su función principal es eliminar la inmunidad mediada por células al final de la reacción inmune y eliminar células T auto-reactivas que escaparon al proceso de selección negativa en el timo. Con lo que tienen un papel muy relevante en el mantenimiento de la homeostasis del sistema inmunitario, favoreciendo la tolerancia hacia autoantígenos; dentro de esto podemos ver la importancia que tienen en evitar la enfermedad injerto contra huésped (EICH) que se desarrolla tras determinados alotrasplantes de tejidos. De modo que pueden ser utilizados para que haya una disminución de esta enfermedad sin que se vea afectado el efecto beneficioso que tiene asociado, que es el efecto injerto contra tumor (EICT).
Otros linfocitos T
- linfocitos t gamma/delta]]': Son un pequeño grupo de células T que poseen un TCR específico en su superficie. La mayor parte de los linfocitos tienen un TCR compuesto por dos cadenas glucoproteicas denominadas α y β. Sin embargo, en las células γδ, el TCR está formado por una cadena γ y una cadena δ. Este grupo de linfocitos es muy poco frecuente (5 % del total), pero son abundantes en la mucosa del intestino, formando parte de una población de linfocitos denominada linfocitos intraepiteliales. Los antígenos que activan estos linfocitos eran desconocidos, se ha descubierto una presentación de glucoproteinas como antígenos, en vez de péptidos. Sin embargo, los linfocitos γδ no presentan restricción CMH, y parece que reconocen proteínas completas en lugar de péptidos, aunque algunos reconocen moléculas CMH-IB.
- Los linfocitos TCR1 se descubrieron recientemente. Suponen solo el 15 % de los T totales, pero no son circulantes, sino que se localizan en ciertos epitelios (por ejemplo, los linfocitos intraepiteliales del intestino). Parece que están especializados en reconocer ciertos patógenos (por ejemplo, micobacterias), que tienden a entrar por las mucosas.[5]
Maduración y selección de las células T

Como pasa con todas las células linfocíticas, las células T provienen de una célula progenitora hematopoyética. Las células progenitoras de los linfocitos T migran desde la médula ósea hacia el timo, donde tiene lugar todo el proceso de maduración, generando células que expresan TCR y CD4 o CD8. Varias etapas definen esa diferenciación:[3]
Reorganización de los genes TCR
- Pro-T. La célula pro-T es el primer precursor de la línea de linfocitos T. Estas células proliferan por efecto de la interleuquina IL-7 producida por las células del timo. En el núcleo de algunas de estas células, se reordenan los genes que codifican la cadena β del TCR, por recombinación mediada por la V(D)J recombinasa. El TCR no se expresa aún en la superficie del pro-T. Tampoco se expresan en la membrana celular las moléculas accesorias CD4 ni CD8. Por esa razón las células pro-T se denominan CD4-/CD8- o dobles negativas.
- - El reordenamiento de la cadena β ocurre al activarse uno de los dos alelos que codifican la cadena β. El otro alelo es inhibido durante el reordenamiento del alelo activado (esto se denomina «exclusión alélica»). Si no se produce una cadena β completa en una célula pro-T, esa célula muere.
- Pre-T. Si la recombinación VDJ tiene lugar con éxito y se sintetiza una cadena β, esta se expresa en la superficie celular, unida a una proteína invariante denominada pre-Tα, para formar el complejo pre-TCR. Por tanto, la célula pre-T es la misma célula pro-T a partir del momento en que la cadena β del TCR se expresa en la superficie celular. La expresión de la cadena β marca el estadio pre-T y al mismo tiempo comienza el reordenamiento de la cadena α. En las pre-T, aún siguen sin expresarse en la membrana celular las moléculas accesorias CD4 ni CD8, así que las células pre-T son CD4-/CD8- o dobles negativas.
- - La expresión en microdominios de la membrana celular de la cadena β unida a la proteína pre-Tα se conoce como pre-TCR y estimula el reordenamiento de uno de los alelos que codifican la cadena α. Si una célula no es capaz de sintetizar una cadena α y el TCR completo, esa célula muere.
Selección positiva de los timocitos
En esta fase tiene lugar la puesta en marcha del mecanismo de restricción CMH: los linfocitos T de un individuo concreto solo pueden detectar un antígeno si este viene presentado por una molécula del complejo mayor de histocompatibilidad CMH (MHC en inglés) del mismo individuo.
Los diferentes clones de timocitos dobles positivos expresan diferentes tipos de TCR αβ. Si el TCR de una célula T reconoce una molécula CMH en el timo (que por definición es una molécula CMH presentando un péptido propio del individuo), esa célula T es seleccionada para sobrevivir: por eso se habla de selección positiva. Para asegurarse de que el linfocito T durante su maduración será expuesto a todo tipo de péptido propio, las células epiteliales medulares del timo expresan numerosos genes, que codifican la mayor parte de las proteínas presentes en los tejidos periféricos.
Las células que no son capaces de reconocer un complejo «péptido propio-CMH» en el timo mueren por apoptosis. Estas células no serían útiles al individuo, porque serían incapaces de ver los péptidos presentados por las moléculas de CMH en los tejidos periféricos.
Elección entre las líneas T CD4+ y CD8+
Durante el proceso de selección positiva, las células T que reconocen complejos péptido-CMH clase-I preservan la expresión de CD8, el coreceptor que se une a la molécula CMH-I, y pierden la expresión de las moléculas de CD4. A la inversa, las células que reconocen complejos péptido-CMH clase-II preservan la expresión de CD4 y pierden la de CD8.
Así, lo que se obtiene al final del proceso de selección positiva son timocitos simples positivos, que son o bien CD8+, restringidos para ver CMH-I, o bien CD4+, restringidos para CMH-II.
Además, durante este proceso, las células T también devienen segregadas funcionalmente: las células T CD8+ pueden convertirse en linfocitos T citotóxicos cuando se activan, mientras que las células T CD4+ serán linfocitos T cooperadores. Se desconoce cómo la selección de co-receptores está asociada a la segregación funcional.
Selección negativa de los linfocitos
Los linfocitos dobles positivos inmaduros, cuyos receptores reconocen fuertemente los complejos «péptido:CMH» en el timo, también sufren apoptosis. Este es el proceso de "selección negativa", que sirve para eliminar linfocitos que podrían reaccionar de forma dañina contra proteínas propias que se expresan en el timo. Por ello, se dice que este mecanismo permite el establecimiento de la tolerancia central, al asegurar que las proteínas propias no serán atacadas por los linfocitos T.
Las células T que han pasado los procesos de selección positiva y negativa son linfocitos maduros, que presentan las siguientes características:
- son positivos simples ya sea CD4+ o bien CD8+;
- están restringidos para las moléculas CMH propias (CD4+ para CMH-II, CD8+ para CMH-I);
- son tolerantes para las proteínas propias;
- son vírgenes (naïves): no han encontrado nunca un antígeno extraño.
Los linfocitos T maduros, salen del timo y se distribuyen por la periferia a través del sistema circulatorio, donde pueden encontrar una célula que presente un complejo «péptido extraño:CMH», capaz de activar el linfocito y desencadenar una respuesta inmune.
Es interesante destacar que la capacidad de reconocer los antígenos extraños por parte de los linfocitos T no está sometida a selección, sino que es el producto del azar: las células T que reconocen los complejos «péptido propio:CMH propio» de forma débil puede que reconozcan fuertemente antígenos extraños, procedentes de microorganismos, en la periferia del organismo.
Activación de linfocitos T

La activación de linfocitos T tiene dos consecuencias generales:
- En el ganglio linfático, la activación de los linfocitos T conduce a la activación de células efectoras inmunes.
- En los téjidos periféricos, la activación de linfocitos T conduce a la erradicación del microorganismo del foco infeccioso. Para ello, los linfocitos deben migrar al foco inflamatorio y experimentar el proceso de diapédesis o extravasación.
Una de las primeras respuestas detectables de los linfocitos T a la presentación y reconocimiento antigénico por células presentadoras de antígeno (CPA) es la secreción de citocinas, en especial la Interleucina-2 (IL-2), la cual actúa como factor de crecimiento sobre el mismo linfocito T que lo secreta, por tener esta receptores para la IL-2. Bajo el efecto de la IL-2, la célula T sufre una proliferación numérica exponencial, denominada expansión clonal, la cual es el fundamento de la memoria inmunitaria. La expansión clonal es seguida por una diferenciación celular, produciendo linfocitos CD4 —encargados de la activación de macrófagos, linfocitos B y otras células— y linfocitos CD8 —las cuales eliminan ciertas «células diana» infectadas y también activan macrófagos en los tejidos afectados—.
Presentación de antígeno
La presentación de antígeno es el proceso por el cual los linfocitos T son activados mediante otras células del sistema inmunitario que les informan de los patógenos presentes. Se realiza mediante la exposición de pequeños fragmentos de la partícula extraña (denominados epítopos) a través del complejo mayor de histocompatibilidad (CMH). Es realizado principalmente por células dendríticas y macrófagos.[6] Puede ser de distintas clases:
- Presentación de clase I: se presentan antígenos intracelulares en contexto del CMH-I. Se activan linfocitos T CD8+ citotóxicos.
- Presentación de clase II: se presentan antígenos extracelulares en contexto del CMH-II. Se activan linfocitos T CD4+ reguladores.
- Presentación cruzada: se presentan antígenos extracelulares en contexto del CMH-I. Se activan linfocitos T CD8+ citotóxicos.

Receptor de la IL-2
La Interleucina-2 es producida por el cuerpo durante una respuesta inmune,[7] cuando un antígeno (sea una molécula o un microorganismo) es reconocido por receptores antigénicos sobre CPA (usualmente una célula dendrítica). La presentación y unión de un pequeño segmento del antígeno, por el HMC, a una célula T por intermedio de su receptor (TCR) estimula la secreción de IL-2 y al mismo tiempo, la expresión de receptores de IL-2 (IL-2R). La subsecuente interacción de IL-2 con IL-2R, estimula el crecimiento, diferenciación y supervivencia de las seleccionadas —por el tipo de antígeno— células citotóxicas, por medio de la activación de genes específicos.[8][9][10] Esto asegura que solo la célula T con el receptor específico al péptido antigénico sea la activada.
Una vez que IL-2 se une a los dominios externos de su receptor, IL-2R, y los dominios internos son activados, la señal de activación continúa hasta que el complejo IL-2/IL-2R es internalizada y degradada. Sin embargo, cada célula tomará el irrevocable cometido de replicar su ADN y pasar por la mitosis y citocinesis solamente cuando un número crítico de IL-2R han sido expresados y activados.[11]
CD28 y B7
La activación de las células T ocurre a través de la interacción, tanto del receptor de la célula T (TCR) y de la molécula CD28 con el complejo mayor de histocompatibilidad (MHC) y la familia de receptores B7 sobre la CPA, respectivamente. Se requieren ambas interacciones para la producción de una respuesta inmune eficaz. En la ausencia de la co-estimulación del CD28, las señalizaciones dirigidas por el TCR reultará en anergia. Desde este punto de activación, las vías de señalización del linfocito T, ocupan muchas proteínas.
IL-12, IL-4
Las moléculas Interleucina-12 e Interleucina-4 juegan un papel importante en la diferenciación de linfocitos T. IL-12 está involucrada en la diferenciación de células CD4+ en células TH1, lo cual es importante en la activación de macrófagos (por medio del interferón gamma) y la destrucción de patógenos. A su vez, IL-4 participa en la diferenciación de linfocitos T en subpoblaciones células TH2.
CD40 y CD40L
La molécula del CD40 es una proteína co-estimuladora presente en la célula presentadora de antígenos (CPA) (un linfocito B, por ejemplo), el cual se une a su ligando, CD40L (CD154) sobre los linfocitos T, activando a la célula, en especial CD4+. Esta interacción CD40:CD40L, a su vez potencia la capacidad de moléculas co-estimuladoras sobre las CPA para actuar en la diferenciación de células T.
Véase también
Galería
Linaje de las células sanguíneas.
Representación 3D de varios tipos de glóbulos blancos.
Referencias
- Dvorkin, Cardinali, Iermoli (2011). «cap:22 Glóbulos blancos y sistema inmunitario». Best y Taylor. Bases Fisiológicas de la Práctica Médica. Médica Panamericana. p. 411. Consultado el 25 de agosto de 2020.
- Hivroz, Claire; Saitakis, Michael (febrero de 2016). «Biophysical Aspects of T Lymphocyte Activation at the Immune Synapse». Front Immunol (en inglés) (Frontiers Media SA) 7: 46. PMID 26913033. doi:10.3389/fimmu.2016.00046. Consultado el 23 de diciembre de 2017.
- Abbas, A.B.; Lichtman A.H. (2009). «Ch.4 Antigen recognition in the adaptive inmune system». Basic Immunology. Functions and disorders of the immune system (3rd edición). Estados Unidos: Saunders (Elsevier). ISBN 978-1-4160-4688-2.
- Dong, Chen; Martinez, Gustavo J. (2010). «T cells: the usual subsets» [Células T: los subtipos comunes] (en inglés). Houston, Texas: Nature Publishing Group. Consultado el 24 de diciembre de 2017.
- http://www.ugr.es/~eianez/inmuno/cap_02.htm
- Neefjes, Jacques; Jongsma, Marlieke L. M.; Paul, Petra; Bakke, Oddmund (11 de noviembre de 2011). «Towards a systems understanding of MHC class I and MHC class II antigen presentation». Nature Reviews Immunology 11: 823-836. doi:10.1038/nri3084.
- Smith, K. (mayo de 1988). «Interleukin-2: inception, impact, and implications». Science 240 (4856): 1169-1176. doi:10.1126/science.3131876.
- Stern, J.; Smith, K. (11 de julio de 1986). «Interleukin-2 induction of T-cell G1 progression and c-myb expression». Science 233 (4760): 203-206. doi:10.1126/science.3523754.
- Beading, C; Johnson, J W; Smith, K A (Apr 1993). «Isolation of interleukin 2-induced immediate-early genes». Proceedings of the National Academy of Sciences of the United States of America 90 (7): 2719-2723.
- Beadling, Carol; Smith, Kendall A (Nov 2002). «DNA array analysis of interleukin-2-regulated immediate/early genes». Medical Immunology 1 (1): 2. doi:10.1186/1476-9433-1-2.
- Cantrell, D.; Smith, K. (Jun 1984). «The interleukin-2 T-cell system: a new cell growth model». Science 224 (4655): 1312-1316. doi:10.1126/science.6427923.
Enlaces externos
Wikimedia Commons alberga una categoría multimedia sobre Linfocito T.- www.aidsmeds.com: Comprende el análisis de las células T
- Linfocitos T (en portugués)

